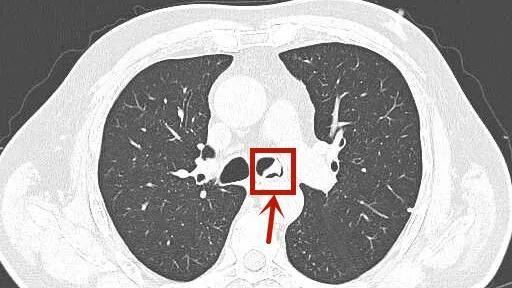
冷报|消失的假牙钩在气管上，老人“心肺都要咳出来”！这些动作不要做

冷报|消失的假牙钩在气管上,老人“心肺都要咳出来”!这些动作不要做
消失的假牙钩在气管上 , 老人“心肺都要咳出来”!这些动作不要做
家住浙江杭州的周大伯 , 虽然平时有咳嗽的老毛病 , 但最近却总是出现莫名的剧烈咳嗽 , 仿佛“心肺都要咳出来” 。 子女送周大伯去医院 , 取出来的东西把全家人吓出一身冷汗 。
70岁大伯“心肺都要咳出来”
消失的假牙竟横在气管里
长三厘米还带钩
今年70多岁的周大伯在多年前就装了假牙 。 自家中近期突遭变故以来 , 周大伯百感交集 , 还曾借酒消愁 。 平时一向生活习惯不错的他 , 也渐渐变得粗心大意 。
子女们虽忙于各自的工作、生活 , 但他们一有时间便来陪伴周大伯 。 近日 , 细心的女儿发现父亲有些“不对劲”“:虽然平时有咳嗽的老毛病 , 但他最近却总是出现莫名的剧烈咳嗽 , 仿佛“心肺都要咳出来” , 甚至还会出现大口喘气依旧呼吸困难的情况 。
文章图片
这些不对劲 , 让子女们都担心不已 , 赶紧把周大伯送到了杭州市第三人民医院呼吸内科 。 接诊的丁凌医生询问后 , 怀疑周大伯的气管内存在异物 , 第一时间安排他做胸部CT检查 。 而结果显示气管内有高密度影 , 高度异物可能!
【冷报|消失的假牙钩在气管上,老人“心肺都要咳出来”!这些动作不要做】可异物究竟是什么?周大伯和家人反复回想 , 都百思不得其解 。

文章图片
呼吸科主任冷报浪仔细阅片 , 立即联系内镜中心 , 紧急为周大伯安排纤维支气管镜检查:气管镜经声门进入 , 果然发现一异物横跨在气管分叉与左主支气管交界处 。
再仔细一瞧 , 它质硬 , 带小钩 , 大小约3*2*1cm , 这不正是周大伯消失的部分假牙么?
在明确周大伯的异物来源后 , 冷报浪开始用异物钳尝试将它取出 。 “由于假牙表面光滑坚硬 , 一次取出难度较大 。 而通过初步探查 , 冷报浪发现 , 假牙的倒钩已有部分嵌入到患者气管内壁 , 如果强行取出或操作不慎可能会刮伤气管壁” 。
只见 , 冷报浪手握气管镜与异物钳娴熟操作 , 他不断仔细调整角度 , 逐步将异物整体松动、分离 , 终于将异物从周大伯的气管中顺利取出 , 避免情况的恶化 。

文章图片
“没想到爸爸这次住院 , 竟然是假牙惹的祸!”内镜中心外 , 周大伯女儿拿着医生取出的假牙后还心有余悸地感叹 。
假牙、辣椒、螺、虾、鸡鸭骨头……
异物误吸到气道非常凶险
这些动作不要再做了!
“作为呼吸科医生 , 气管镜取异物这样的手术方式是比较常见的 。 ”

文章图片
冷报浪介绍 , 科室几乎每月都会收治气管异物患者 , 取出物品不仅有假牙 , 还有金属物、辣椒、豆类、螺、虾、鸡鸭骨头、红烧肉块等 , 堪比“杂货箱” 。 虽然部分异物很小 但它被误吸入气管、支气管内且无法自行咳出 , 可影响患者呼吸 , 随着时间推移继发感染加重病情 , 严重时可危及生命 。
冷报浪提醒 , 老年人吃东西时可能毫无察觉地误吞误吸假牙并继续进食 , 尤其是无法与人交流的老人更危险 。 不要给佩戴假牙的人吃黏性较大的食物 , 如年糕、糍粑、汤圆等 , 吃饭细嚼慢咽 。 不要再戴着活动假牙入睡 , 以防半夜误吸 。 有条件的老人 , 尽量镶固定假牙 , 并定期去医院检查 , 出现松动或是到时间了 , 都要及时更换 。
- 口味|给孩子做个“快手菜” 营养丰富,口味独特,提高身体的免疫力
- 潜伏在我们身边的这3种“致癌”蔬菜,看完你还敢继续吃吗?
- 隔离|如何帮治疗、隔离中的孩子做好心理调适?专家给出建议
- 饮食习惯|咸鱼腊肉很好吃,但吃多了真的会致癌?牢记3点,或无后顾之忧
- 患上糖尿病|隔代也会遗传糖尿病?关于糖尿病的5个冷知识,你了解多少?
- 宜温阳|郭德尚:肝硬化腹水的主要病机
- 治疗|糖尿病服药后,出现的低血糖比较严重怎么办?
- 进行|尿毒症多半是“吃”出来的?3种食物尽量少碰,肾或许“感谢”你
- 过量食肉带来的危险 你知道么
- 生活|提醒:肝病多数是“拖”出来的,出现6种表现,最好查一下肝功
